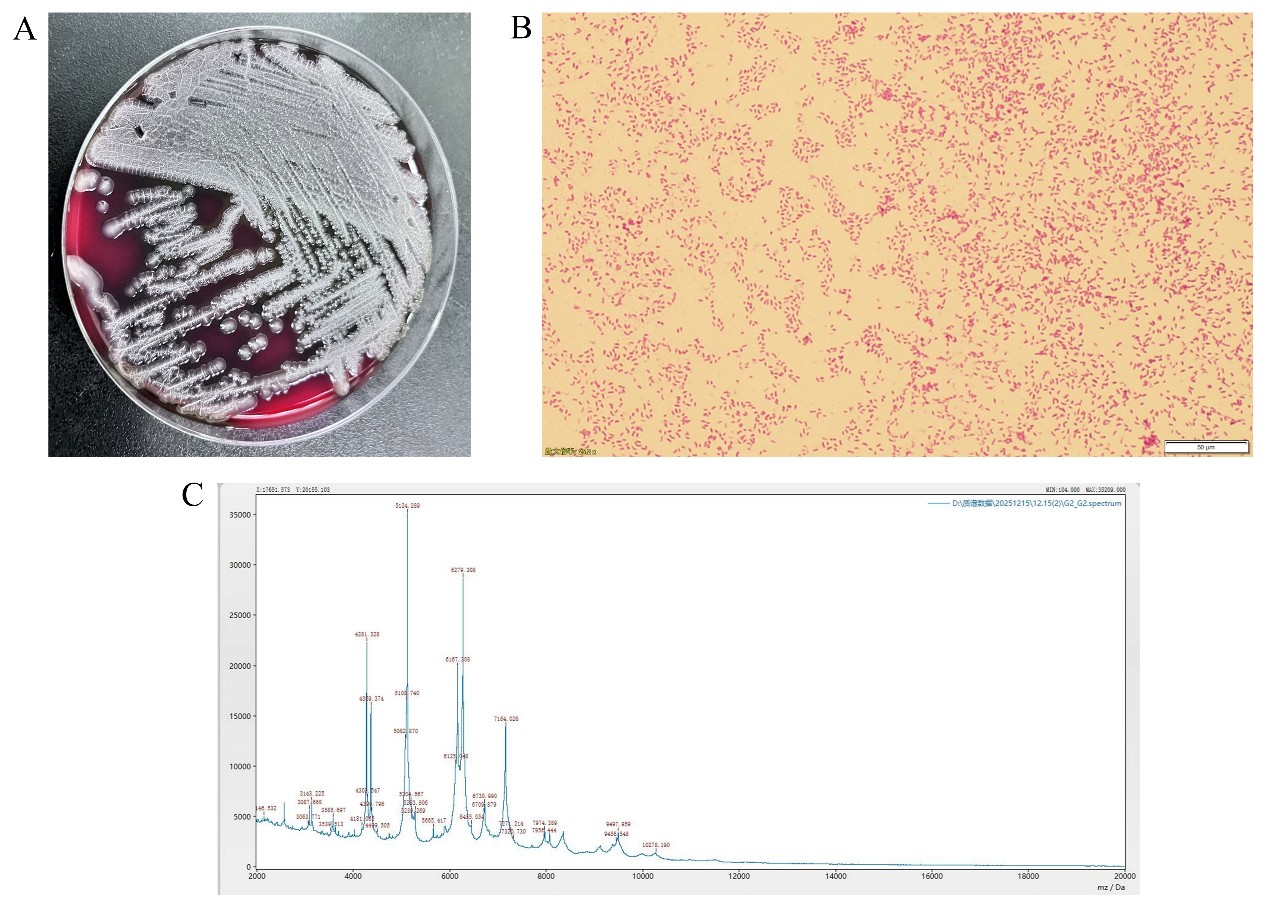

nephrin抗体相关足细胞病合并非o1/非o139型霍乱弧菌感染1例
引 言 足细胞病是一种以足细胞结构或功能异常为核心特征的病理诊断,属组织学描述范畴,而非病因学诊断。其已知病因除原发免疫性外,还包括继发免疫性、遗传性、获得性、感染性、单克隆性及中毒性因素等【1】。抗Nephrin抗体是新近发现的原发免疫性足细胞病标志抗体,被认为可用于辅助诊断并监测其疾病活动度【2】。通过免疫抑制或血浆置换清除该抗体是治疗策略之一,但治疗过程中需警惕感染风险。非O1/非O139型霍乱弧菌感染在健康人群中发生率较低,而在肝硬化、糖尿病和恶性肿瘤等免疫功能低下患者中相对多见【3】。目前尚无肾病综合征患者在接受免疫抑制剂治疗后发生非O1/非O139型霍乱弧菌菌血症的报道。本文报道一例Nephrin抗体相关性足细胞病患者在治疗过程中并发非O1/非O139型霍乱弧菌感染,经综合治疗后取得良好效果,以期为类似患者的临床诊治提供参考。 临床资料 一、一般资料 现病史:患者20天前出现颜面部、双下肢浮肿,为重度凹陷性,不伴尿量减少,于外院诊治见尿蛋白3+,血清白蛋白17.4g/L,血常规、肾功能未见明显异常。肾脏病理提示为微小病变(MCD)型,予以甲泼尼龙50mg qd以及抗凝等治疗共两周左右,患者浮肿无改善,血清肌酐逐步升高(出院前147.5μmol/L),为求进一步诊治转入我院治疗。 既往史、个人史、家族史均无特殊。 体格检查:体温36.2℃,脉搏72次/分,呼吸20次/分,血131/90mmHg。腹部及下肢皮肤可见紫纹,心肺(-),腹部平坦,全腹无压痛及反跳痛,颜面部和双下肢重度对称性凹陷性水肿。 二、辅助检查 入院前外院资料示:尿蛋白3+,血清白蛋白17.4g/L,血常规、肾功能未见明显异常,腹主动脉、下腔静脉、双侧髂总及髂外动静脉、双肾静脉彩超均未见明显异常。病理检查:光镜及免疫荧光:肾穿刺组织可见10个肾小球。肾小球系膜细胞和基质轻度增生,节段性毛细血管基底膜呈空泡变性。肾小管上皮细胞呈颗粒与空泡变性;肾间质与小动脉无明显异常(图1A-E)。免疫荧光检查:未见小球结构,刚果红染色(-)。电镜:电镜下肾小球基底膜节段性增厚,足突弥漫性融合,个别系膜区可见少量电子致密物沉积。肾脏病理见广泛足突融合(图2A-B)。外院诊治两周后(出院前)复查结果示:尿蛋白2+,血清白蛋白11.3g/L,尿素20.37mmol/L,肌酐147.5μmol/L,尿酸532.2μmol/L,总胆固醇12.93mmol/L,甘油三酯3.34mmol/L,高密度脂蛋白胆固醇2.6mmol/L,低密度脂蛋白胆固醇8.57mmol/L。

图1肾脏组织光镜图 A.HE染色(x100);B.Masson染色(x200);C.PASM染色(x200);D.PAS染色(x200)

入院后检查:24小时尿蛋白定量14562mg/1500ml,血清白蛋白13g/L,低密度脂蛋白胆固醇8.25mmol/L,高密度脂蛋白胆固醇1.56mmol/L,总胆固醇11.46mmol/L,甘油三酯2.73mmol/L,血清肌酐243μmol/L,尿素23.04mmol/L,大便OB、抗核抗体、抗磷脂酶A2受体抗体、IgG4、肿瘤标志物以及输血前传染病检查等均未见异常。抗Nephrin抗体597 U/mL(参考值:<45 U/mL)。
三、诊断及鉴别诊断
诊断:Nephrin抗体相关足细胞病 肾病综合征 急性肾损伤
鉴别诊断:遗传性肾病。部分遗传性肾病可表现为肾病综合征,多在儿童/青少年起病,常伴或不伴家族史;除肾病综合征外,可能合并耳聋、眼部异常等系统表现;对常规免疫抑制治疗抵抗,减停药后易复发;仅凭肾脏病理往往难以确诊,需进行致病基因检测明确诊断。
四、治疗
起始予以甲泼尼龙40mg qd、辅以依诺肝素抗凝、制酸护胃、补钙、间段补充白蛋白等治疗,抗Nephrin抗体阳性结果回报后,考虑加强免疫抑制治疗。经与患者及家属沟通了免疫抑制剂(他克莫司、CD20单抗、环磷酰胺)的相关风险利弊后,家属首先选择加用他克莫司1.0mg q12h,但使用两天后复查血清肌酐进一步升高(由入院时243μmol/L上升到300μmol/L),遂停用,改为使用环磷酰胺0.2g、0.4g、0.4g(隔日静注)1周患者AKI进一步加重(少尿,严重水肿),体查可见左侧腰部及右足背部皮肤自发性破裂及渗液,复查血清肌酐为352μmol/L,改为间段进行连续肾脏替代治疗(CRRT),后尿量恢复,复查血清肌酐逐步恢复正常,血清白蛋白12g/L。免疫治疗方案调整利妥昔单抗200mg,并加用磺胺甲噁唑预防肺孢子菌感染,观察2天无异常不适后出院,嘱服用泼尼松50mg qd,拟2周后返院继续行利妥昔单抗治疗。
五、治疗结果、随访及转归
出院当日晚上患者因“发热,腹泻5小时”再次由急诊途径收入我科,最高体温达39.6℃,询问病史当天有可疑不洁饮食及受凉病史,查血白细胞计数12.52x 10^9/L、中性粒细胞9.8 10^9/L、降钙素原2.061 ng/mL、血清白蛋白13.7g/L、肌酐76μmol/L、尿素8.85mmol/L、24h尿蛋白12013.2mg/4700ml。予以美罗培南抗感染、补充白蛋白、激素减量等治疗,1天后体温降至正常,后续血培养结果提示为霍乱弧菌(图3A-C),血清凝集实验提示为非O1/非O139型。继续抗感染治疗待体温维持稳定一周后,在前次使用利妥昔单抗后的第10天再次予以利妥昔单抗200mg,复查血清白蛋白16.9g/L,抗Nephrin抗体阴性,安排出院。后续患者遵医嘱每半月返院行利妥昔单抗治疗(小剂量4次静脉治疗,总计量1800mg),复查肾功能均无异常,血清白蛋白分别为:22.2g/L、25.4g/L、29.3g/L、33.9g/L,24小时尿蛋白定量/尿量分别为:3327mg/2000ml、8090mg/2750ml、4992mg/3000ml、5352mg/3250ml,期间查三次治疗期间抗Nephrin抗体均为阴性(图4)。

讨 论
我们报道了一例青少年肾病综合征,肾脏病理表现为MCD,外院足量糖皮质激素治疗后无好转,血清肌酐轻度升高。入我院后考虑需明确是否为原发免疫性足细胞病,予以检测Nephrin抗体,结果为强阳性。遂在糖皮质激素的基础上联合他克莫司(仅2天)以及环磷酰胺(1.0g)治疗,出现较为严重AKI,间断进行CRRT治肾功能恢复,后使用联合利妥昔单抗治疗,患者全身浮肿较前好转, 24h尿蛋白逐渐减少,白蛋白逐渐升高。治疗过程在第一次使用利妥昔单抗200mg后,患者出院当天发生血源性非O1/非O139型霍乱弧菌感染,抗感染治疗后快速恢复,后续再次使用利妥昔单抗200mg后复查Nephrin抗体为转阴性,且后续治疗过程中未再转为阳性。
足细胞病是一种以足细胞结构或功能异常为核心特征的病理诊断,属于组织学描述范畴,而非病因学诊断。目前已知的足细胞损伤病因主要包括原发免疫性、继发免疫性、遗传性、获得性、感染性、单克隆性及中毒性因素等【1】。在原发免疫性足细胞病中,学者提出了“免疫循环因子”假说,认为循环中存在可介导足细胞损伤并的免疫因子。围绕该假说,学界已开展了大量研究,旨在筛选和鉴定这些潜在的致病因子。
Nephrin是足细胞裂孔隔膜的关键跨膜蛋白,与其他蛋白等共同构成“分子筛”,决定肾小球滤过屏障的选择性通透性,阻止中大分子漏出,维持足突的有序排列与形态稳定【4】。多项实验显示,Nephrin基因敲除【5】或注射Nephrin中和抗体【6, 7】,均可诱导啮齿类动物足细胞病变和大量蛋白尿,提示Nephrin蛋白缺失可能是足细胞病的致病原因之一,Nephrin抗体则参与了其病理生理过程。有研究最初在部分肾病综合征以及MCD患者的血液中检测到Nephrin抗体【8】,随后,一项涵盖成人与儿童肾病综合征患者的大样本研究进一步报道44%的成人MCD患者、9%的成人局灶性节段性肾小球硬化症(FSGS)患者以及52%的儿童特发性肾病综合征患者体内存在抗Nephrin抗体,而在其它类型的肾病中基本无检出,具有较高特异性,因为被认为是一种新的足细胞肾病标志物【2】。进一步的,他们对儿童肾病综合征的调查显示,68%的激素敏感型患者,28%的激素依赖型患者以及14%非基因突变的激素抵抗型患者存在抗Nephrin抗体,而仅有2%的基因突变激素抵抗型患者存在抗Nephrin抗体,提示抗Nephrin抗体可用于辅助鉴别遗传性肾病综合【9】。
现有研究进一步发现Nephrin抗体在活动期足细胞病中检出率高,尤其在未接受免疫抑制治疗的初诊患者中可达到90%;线性重复测量模型分析也显示Nephrin抗体阳性与蛋白尿水平呈显著正相关性【2】。研究还发现肾移植后复发的肾病综合征患者肾活检标本和血清中均可检测到Nephrin抗体;对于在移植前和疾病复发时血清中Nephrin抗体阳性的患者,移植后更易早期发生大量蛋白尿,而通过治疗后Nephrin抗体转阴,蛋白尿随着抗体消失实现持续缓解,提示Nephrin抗体水平与移植后MCD或FSGS也呈正相关【8, 10】。进一步地,赵明辉教授团队研究发现,在达到临床缓解时,91.7%的MCD患者与86.7%的FSGS患者抗Nephrin抗体转阴,而抗体水平的再次阳性可在蛋白尿复发前1-4个月出现【11】。因而Nephrin抗体可作为Nephrin抗体相关足细胞病患者疾病活动性的指标,而清除该抗体成为一种潜在的治疗方法。有研究报道了一例激素抵抗型Nephrin抗体相关足细胞病病例,通过联合应用血浆置换、利妥昔单抗和霉酚酸酯治疗,患者临床表现好转,尿蛋白及Nephrin抗体均转阴【12】。我们的病例入院后检测Nephrin抗体阳性,先经过了全程糖皮质激素、2天他克莫司、1.0g环磷酰胺以及数次CRRT治疗,序贯使用了利妥昔单抗200mg,10天后复查Nephrin抗体转阴,临床症状和检测指标缓解。该病例的改善可能是利妥昔单抗介导的B细胞耗竭抑制了Nephrin抗体产生有关,但不排除糖皮质激素/环磷酰胺的延迟效应。
此外值得注意的是,我们的病例第一次出院后当天晚上因“发热、腹泻”再次由急诊入院,后续血培养的结果为非O1/非O139型霍乱弧菌阳性。霍乱弧菌是一种革兰阴性、兼性厌氧的弯曲杆菌,根据其表面O抗原进行分型,迄今为止已发现超过200个血清群【3, 13】,其中O1和O139血清型是引起霍乱流行的主要原因。非O1/非O139群霍乱弧菌是除O1和O139 血清群以外霍乱弧菌的总称,其不产生霍乱毒素,也不会引起霍乱大流行,通常引起自限性胃肠炎,但也可引起肠道外感染,如菌血症、胆道感染、尿道感染、皮肤伤口感染以及眼、耳感染等【14, 15】。在免疫功能正常的人体中,非O1/非O139型霍乱弧菌引起的菌血症较少见,但调查发现在肝硬化、糖尿病和恶性肿瘤等免疫力低下的患者中其发生率有所提高【3】。据我们检索,目前尚无肾病综合征患者使用免疫抑制剂后发生非O1/非O139型霍乱弧菌菌血症的报道。及时血培养和准确鉴定对这类患者的诊断非常重要,早期应用敏感抗生素治疗预后相对较好。通常认为被污染的食物或饮水是感染非O1/非O139群霍乱弧菌最可能的感染源,通过追问病史,我们的患者出院当天中午有可疑不洁食物食用史,这可能是导致患者菌血症的原因。
总之,本研究报道了1 例合并霍乱弧菌感染的Nephrin 抗体相关足细胞病的治疗经过。随着Nephrin 抗体检测技术的不断进步,检测的准确度与可靠性持续提升,基于该抗体的血清学检测有望以无创方式实现对此类足细胞病的诊断与活动度监测,从而推动疾病管理模式的优化;对于抗拒或存在禁忌证行肾穿刺的患者,以及足细胞病复发后面临重复肾穿刺抗拒/禁忌者,尤为适用。
参考文献
1. Romagnani P, Tang SCW, Weins A, Huber TB, Osafo C, Anders H-J. Podocytopathies. Nature Reviews Disease Primers. 2025;11(1).
2. Hengel FE, Dehde S, Lassé M, Zahner G, Seifert L, Schnarre A, et al. Autoantibodies Targeting Nephrin in Podocytopathies. New England Journal of Medicine. 2024;391(5):422-33.
3. Li X, Wu Y, Sun X, Ma J, Li X, Liu C, et al. Non-O1/non-O139 Vibrio cholerae bacteraemia in mainland China from 2005 to 2019: clinical, epidemiological and genetic characteristics. Epidemiology and Infection. 2020;148.
4. Grahammer F, Schell C, Huber TB. The podocyte slit diaphragm—from a thin grey line to a complex signalling hub. Nature Reviews Nephrology. 2013;9(10):587-98.
5. Li X, Chuang PY, D’Agati VD, Dai Y, Yacoub R, Fu J, et al. Nephrin Preserves Podocyte Viability and Glomerular Structure and Function in Adult Kidneys. Journal of the American Society of Nephrology. 2015;26(10):2361-77.
6. Hengel FE, Dehde S, Kretz O, Engesser J, Zimmermann T, Huber TB, et al. Passive transfer of patient-derived anti-nephrin autoantibodies causes a podocytopathy with minimal change lesions. Journal of Clinical Investigation. 2025;135(5).
7. Takeuchi K, Naito S, Kawashima N, Ishigaki N, Sano T, Kamata K, et al. New Anti-Nephrin Antibody Mediated Podocyte Injury Model Using a C57BL/6 Mouse Strain. Nephron. 2018;138(1):71-87.
8. Watts AJB, Keller KH, Lerner G, Rosales I, Collins AB, Sekulic M, et al. Discovery of Autoantibodies Targeting Nephrin in Minimal Change Disease Supports a Novel Autoimmune Etiology. Journal of the American Society of Nephrology. 2022;33(1):238-52.
9. Hengel FE, Dehde S, Yilmaz A, Bayazit AK, Ozaltin F, Paripovic D, et al. Anti-nephrin autoantibodies in steroid-resistant nephrotic syndrome may inform treatment strategy. Kidney International. 2025;107(6):1099-103.
10. Shirai Y, Miura K, Ishizuka K, Ando T, Kanda S, Hashimoto J, et al. A multi-institutional study found a possible role of anti-nephrin antibodies in post-transplant focal segmental glomerulosclerosis recurrence. Kidney International. 2024;105(3):608-17.
11. Shu Y, Huang J, Jiang L, Zhang Y-m, Wang F, Wang X, et al. Anti-nephrin antibodies in adult Chinese patients with minimal change disease and primary focal segmental glomerulosclerosis. Kidney International. 2025;108(3):433-44.
12. Takizawa K, Shirai Y, Kajiho Y, Kanda S, Kato M, Abe H, et al. Treatment of Nephrotic Syndrome With Antinephrin Antibodies Using Plasmapheresis, Rituximab, and Mycophenolate Mofetil. Kidney International Reports. 2025;10(5):1591-3.
13. Rodríguez JY, Duarte C, Rodríguez GJ, Montaño LA, Benítez-Peñuela MA, Díaz P, et al. Bacteremia by non-O1/non-O139 Vibrio cholerae: Case description and literature review. Biomédica. 2023;43(3):323-9.
14. Maraki S, Christidou A, Anastasaki M, Scoulica E. Non-O1, non-O139 Vibrio cholerae bacteremic skin and soft tissue infections. Infectious Diseases. 2015;48(3):171-6.
15. Baker-Austin C, Oliver JD, Alam M, Ali A, Waldor MK, Qadri F, et al. Vibrio spp. infections. Nature Reviews Disease Primers. 2018;4(1):1-19.






